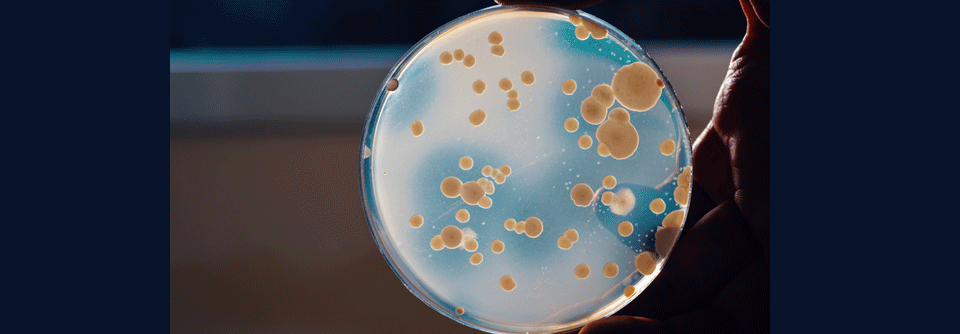

Hepatitis C: Therapie für Patienten mit Zirrhose, Leberkrebs oder Niereninsuffizienz
 Bis 2030 will die WHO die Prävalenz von Hepatitis C um 90 % senken.
© fotolia/Kateryna_Kon
Bis 2030 will die WHO die Prävalenz von Hepatitis C um 90 % senken.
© fotolia/Kateryna_Kon
Um 90 % soll die Hepatitis-C-Prävalenz bis 2030 sinken – das hat sich die Weltgesundheitsorganisation zum Ziel gesetzt. Da es bislang keinen Impfstoff gibt, braucht es ein intensives Screening und die antivirale Therapie, betont Professor Dr. Stefan Zeuzem vom Universitätsklinikum Frankfurt am Main. Die Indikation für direkt antivirale Substanzen besteht grundsätzlich bei allen Patienten mit chronischer Hepatitis C. Derzeit stehen drei Medikamentenklassen zur Verfügung (s. Kasten), die man hierzulande typischerweise in koformulierten, fixen Regimes einsetzt:
Pangenotypisch:
- Glecaprevir/Pibrentasvir
- Sofosbuvir/Velpatasvir
Genotypen-restringiert:
- Sofosbuvir/Ledipasvir
- Grazoprevir/Elba…
Liebe Leserin, lieber Leser, aus rechtlichen Gründen ist der Beitrag, den Sie aufrufen möchten, nur für medizinische Fachkreise zugänglich. Wenn Sie diesen Fachkreisen angehören (Ärzte, Apotheker, Medizinstudenten, medizinisches Fachpersonal, Mitarbeiter der pharmazeutischen oder medizintechnischen Industrie, Fachjournalisten), loggen Sie sich bitte ein oder registrieren sich auf unserer Seite. Der Zugang ist kostenlos.
Benutzeranmeldung
Bitte geben Sie Ihren Benutzernamen und Ihr Passwort ein, um sich an der Website anzumelden.
Bei Fragen zur Anmeldung senden Sie bitte eine Mail an online@medical-tribune.de.
Bereiche
- Allergologie
- Allgemeinmedizin
- Alternativmedizin
- Angiologie
- Chirurgie
- Dermatologie
- Diabetologie
- Endokrinologie
- Gastroenterologie
- Geriatrie
- Gynäkologie
- HNO
- Infektiologie
- Innere Medizin
- Kardiologie
- Naturheilkunde
- Nephrologie
- Neurologie
- Onkologie und Hämatologie
- Ophthalmologie
- Orthopädie
- Pädiatrie
- Palliativmedizin und Schmerzmedizin
- Pneumologie
- Psychiatrie
- Rheumatologie
- Sportmedizin
- Urologie
- Alle Beiträge
- Kongress aktuell